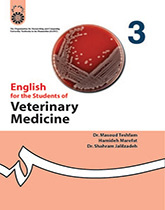
انگلیسی برای دانشجویان رشته دامپزشکی

انگلیسی برای دانشجویان رشته دامپزشکی
English for the Students of Veterinary Medicine
1. The Skeletal System
2. Vertebrate Embryology
3. Support Cells and Extracellular Matrix
4. The Reproductive System
5. Hepatobiliary System
6. Special Senses: Ear
7. Nutrition and Health of Cattle
8. Parturition
9. Meat Hygiene Practise
10. Post-Mortem Inspection
11. Physical Examination of Urine
12. Blood Groups, Immunogenetics, and Biochemical Genetics
13. Pulmonary Oedema and Haemorrhage
14. Alterations in Alimentary Function
15. Vomiting
16. Colic
17. Subclass Coccidia
18. Sarcocystidae
19. Brucellosis
20. Newcastle Disease
این کتاب برای دانشجویان رشته دامپزشکی در مقطع دکترای حرفهای به عنوان منبع اصلی درس «زبان تخصصی» به ارزش 4 واحد تدوین شده است.




نظر شما :